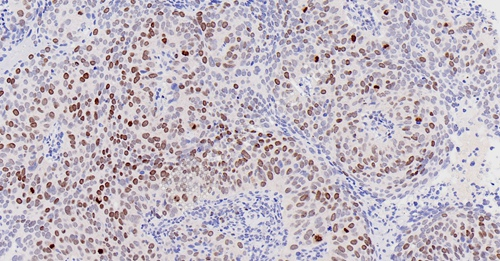

服务项目
免疫组化(组织芯片)
服务概述
组织芯片免疫组化染色,是将多种组织以规则的微阵列方式排列于同一载体上,同时进行相同指标的免疫组化检测。组织芯片具有体积小, 标本信息含量大 , 一次性实验即可获大量结果。实验条件更易控制一致,减少批间批内误差,结果更准确。节省试剂,节省人力物力等优点。
服务周期:
技术介绍
组织芯片免疫组化染色,是将多种组织以规则的微阵列方式排列于同一载体上,同时进行相同指标的免疫组化检测。组织芯片具有体积小, 标本信息含量大 , 一次性实验即可获大量结果。实验条件更易控制一致,减少批间批内误差,结果更准确。节省试剂,节省人力物力等优点。
实验流程
1. 切片脱蜡至水-抗原修复-3%的双氧水处理-画圈-血清封闭-一抗4℃过夜孵育-二抗室温孵育-显色-苏木素染核-脱水、透明、封片-镜检
实验步骤
步骤1:标准化取材
使用组织芯片打孔仪在供体蜡块中精准获取直径1-2mm的圆柱形组织,按预定阵列排布于受体蜡块中
案例:实验结果展示
H鳞癌-KI67_0.4x
H鳞癌-KI67_5.8x

H鳞癌-KI67_14.3x
人甲状腺芯片-FOXA1_0.4x
人甲状腺芯片-FOXA1_2.2x
人甲状腺芯片-FOXA1_12.8x
结果判读
阳性信号为棕黄色颗粒状沉积,细胞核增殖标志物(如Ki67)定位在细胞核,细胞质/膜标志物(如FOXA1)需对应亚细胞定位。采用半定量评分系统:染色强度(0-3分)乘以阳性细胞百分比(0-4级),总分0-12分判定为阴性/弱阳性/阳性/强阳性。
送样运输要求
石蜡样本需用防震海绵包裹,冰袋冷链运输;冰冻样本必须置于干冰运输,运输时间不得超过72小时。样本需标注患者编号、取材部位、固定时间等信息。
注意事项
- 石蜡切片制片时,组织取样后应立即放入4%中性甲醛固定液中,避免冻存导致冰晶形成
- 冰冻切片需在-20℃条件下用OCT包埋剂快速包埋,切片厚度建议4-5μm
- 组织蜡块可长期保存于15-25℃干燥环境,已切片石蜡片应避免高温高湿,建议6个月内完成染色